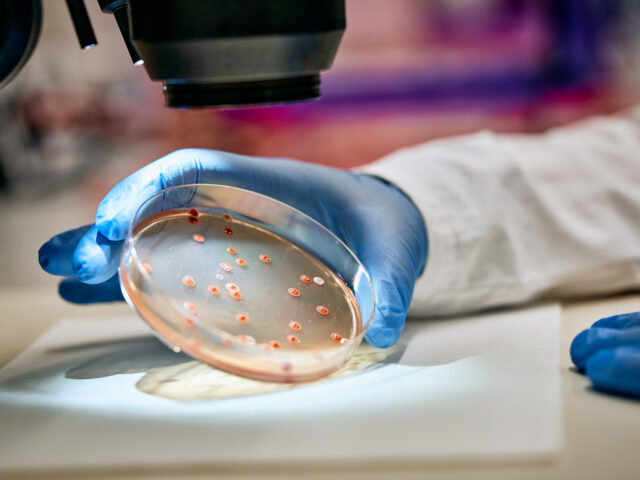
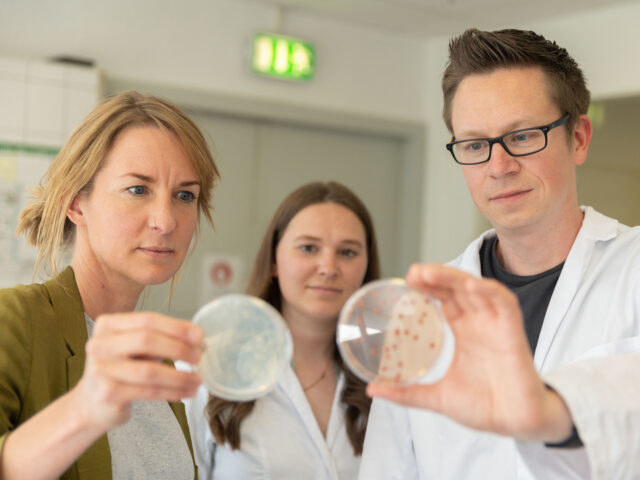

Bio? Logical!
Naturally sustainable: Biological seed treatments as an alternative to synthetic crop protection.
Crop protection regulations and increased ambitions for more sustainability in agriculture are bringing biological seed treatments into greater focus. Biologicals derived from beneficial microorganisms or substances of natural origin are playing an increasingly important role at KWS.
Seeds are particularly sensitive to diseases and pests immediately after sowing. To protect them from external stress factors and promote their development, seeds are often coated with a dressing. These treatments may contain synthetic or biological plant protection agents, explains Nora Temme, Biologicals Manager at KWS. “Biologicals constitute a meaningful addition to synthetic seed treatments,” she adds. “In applying them, we leverage beneficial interactions and stimuli from nature and systematically use them for our crop varieties.” Biologicals consist of helpful microorganisms such as bacteria or fungi as well as other natural substances (for example, plant extracts). They are systematically applied to seed and can effectively protect the seedling with very low doses – for example, acting as biological crop protection, improving nitrogen fixation and promoting the plants’ vigor and plant development. In this way, biologicals make an important contribution to enabling the reduction of fertilizers and crop protection as specified by lawmakers.
First market-ready KWS product for sugarbeet
Since 2018, KWS has been driving forward the development of specific biologicals – and has achieved success. Up to now, many microorganisms would have had to be applied to the seed immediately before sowing. But KWS has teamed up with Biotenzz, a spin-off of the Technical University of Graz, to develop a special stabilization process using BFC technology: The bacteria are first embedded into microscopic beads and then applied directly to the seed. It is a breakthrough in the industry. The first market-ready product based on this process is a biostimulant for sugarbeet. It combines six strains of bacteria specifically selected for sugarbeet that, among other qualities, support juvenile plant development as well as yield potential under stress conditions such as drought or cold. Varieties treated using the new technology have been available since 2022 in initial European countries. Additional biologicals based on this technology will follow for other crops such as rye and oilseed rape.
We’re gaining an increasingly better understanding of the effect of biologicals and can optimize them with a range of technologies that unleash their full potential as seed treatment. Our goal is to further develop biologicals for all KWS crops.
Nora Temme | Biologicals Manager at KWS
KWS is also looking for solutions outside of agriculture, as Nora Temme explains: “There are applications in the food industry that work in seed treatment as well. Natural preservatives from milk and cheese production are also very well suited for seed protection.” The biggest challenge so far is applying a lasting and stable coating of the sensitive microorganisms to the surface of the seeds. Only then can they survive the process of treatment and long-term storage. KWS is convinced that similar processes will offer solutions for both conventional and organic farming in the future: “We’re gaining an increasingly better understanding of the effect of biologicals and can optimize them with a range of technologies that unleash their full potential as seed treatment,” Temme states. “Our goal is to further develop biologicals for all KWS crops. In the future, it’s possible that biostimulants and biological crop protection will not only complement synthetic seed treatment, but even replace it.”
KWS: Protect the seed with biologicals – ecologically and sustainably
KWS Background
INITIO, naturally.
KWS also offers biological seed treatment as part of its INITIO product range for oilseed rape, corn, cereals and vegetables. The treatment currently used for these products contains natural substances or microorganisms from the class bacilli that are well suited for treatment. KWS is working on additional solutions and technologies so it can also offer an even broader portfolio of beneficial microorganisms for these crops in the future.